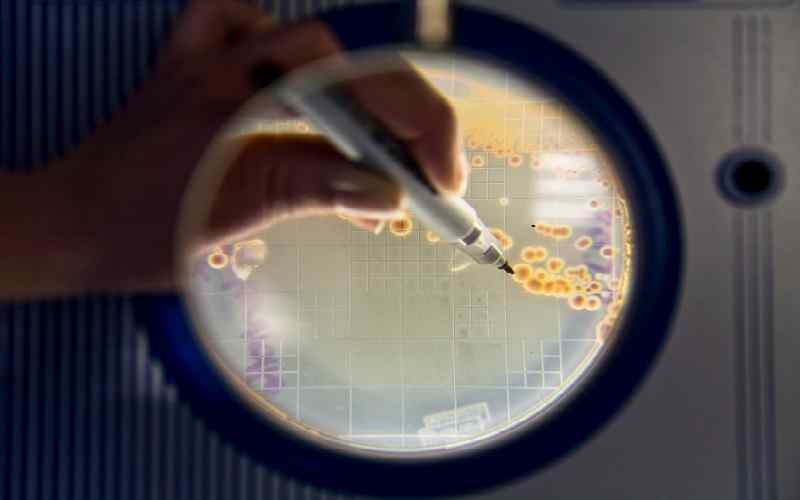

Danh mục sản phẩm
- Sơn và Mực in
- Chất tạo màng
- Hoàn thiện bề mặt kim loại
- Polymer
- Phụ gia thực phẩm
- Hóa dầu
- Thiết bị
- Trang thiết bị y tế
-
Viên gỗ nén
Tìm kiếm sản phẩm
Sơn & Mực in
Các loại phụ gia kháng khuẩn sử dụng trong sản xuất sơn
Hình minh họa
Các loại chất diệt khuẩn chính được sử dụng trong sơn & lớp phủ
Chất bảo quản
Tất cả các loại sơn nước đều chứa chất dinh dưỡng cho vi khuẩn, nấm và nấm men. Do đó, sự tấn công của vi sinh vật có thể xảy ra bên trong lon, điều này sẽ ảnh hưởng đến chất lượng của sơn. Khi nó xảy ra, bạn có thể trải nghiệm:
- Chất bảo quản trong có thể cho sơn và lớp phủ
- Mùi hôi
- Mất độ nhớt
- Gassing
- Tách pha
- Đổi màu
- Giảm độ pH
Để bảo vệ lớp phủ của bạn khỏi những vấn đề như vậy và kéo dài tuổi thọ lưu trữ của lớp phủ, bạn phải sử dụng Chất bảo quản trong hộp. Chúng là vật liệu hữu cơ. Chúng được sử dụng ở mức thấp; <0,1% trọng lượng thường.
Một chất diệt khuẩn cho sản phẩm đựng trong hộp hiệu quả phải có các đặc tính sau:
- Hiệu quả kháng khuẩn phổ rộng
Đo Nồng độ Ức chế Tối thiểu (MIC) là một cách tốt để kiểm tra hiệu quả của chất diệt khuẩn. MIC là nồng độ chất bảo quản thấp nhất mà tại đó sự phát triển của sinh vật thử nghiệm bị ức chế trong điều kiện phòng thí nghiệm.
- Bảo vệ lâu dài
Sơn có thể được bảo quản trong thời gian dài và chịu sự thay đổi nhiệt độ rộng. Chỉ có thể đạt được khả năng bảo quản tối ưu nếu chất bảo quản trong hộp tương thích với các thành phần của lớp phủ và ổn định theo thời gian.
Tác nhân chống bám cặn
Chất chống hà cho lớp phủ hàng hải. Đây là chất đặc biệt cho lớp phủ hàng hải hoặc sơn chống hà. Mục đích là để tránh các sinh vật biển như tảo và động vật thân mềm bám vào tàu. Nếu không, chúng sẽ ảnh hưởng đến hiệu suất của tàu (tốc độ, khả năng cơ động, tiêu thụ nhiên liệu).
Chất chống đóng cặn bao gồm cả hóa chất hữu cơ và vô cơ. Việc sử dụng một số hóa chất bị hạn chế về mặt địa lý vì ảnh hưởng của chúng đối với động vật hoang dã biển, vì vậy hãy đảm bảo tuân thủ các hướng dẫn quy định về hóa học cũng như mức độ sử dụng.
Mildewcide / Chống nấm
Chất diệt nấm mốc và vật liệu chống nấm được sử dụng trong tất cả các lớp phủ bên ngoài, nơi bất kỳ độ ẩm nào sẽ thúc đẩy sự phát triển của các sinh vật, chẳng hạn như nấm mốc, nấm mốc và các loại nấm khác. Sơn cho các ứng dụng nội thất nơi có độ ẩm cao hơn, chẳng hạn như nhà bếp và đặc biệt là phòng tắm, cũng sử dụng chất diệt nấm mốc.
Chất diệt khuẩn cho lớp phủ màng khô vì nấm mốc và vi khuẩn sẽ phát triển ngay cả trên thủy tinh khi có nước, các chất phụ gia để ngăn vi sinh vật hình thành khuẩn là điều cần thiết để giữ cho lớp phủ trông nguyên sơ và không bị đổi màu do nấm mốc phát triển.
Oxit kẽm (ZnO) cho đến nay là vật liệu vô cơ phổ biến nhất được sử dụng. Có một số quy trình được sử dụng để sản xuất ZnO và điều quan trọng là phải điều chỉnh mức sử dụng dựa trên loại do sự phân bố kích thước hạt và do đó khả năng phản ứng với các thành phần lớp phủ.
Nhiều vật liệu hữu cơ hoạt động tốt một mình hoặc tốt hơn khi kết hợp với ZnO, giả sử ZnO có thể ổn định. Các chất hữu cơ được xem xét kỹ lưỡng và bắt buộc rằng bất kỳ chất nào được sử dụng để tạo thành lớp phủ phải phù hợp với khí hậu, nhưng quan trọng nhất là chúng phải được cơ quan quản lý chấp thuận về mặt địa lý.
Các loại phụ gia chống vi khuẩn khác
Vật liệu nano cũng được sử dụng để ngăn chặn sự phát triển của vi sinh vật - Bạc (Ag) được sử dụng thường xuyên hơn các loại khác.
Hiệu quả của các sản phẩm bạc như vậy dựa trên sự rửa trôi chậm và liên tục của các ion bạc siêu mịn tương tác với sự trao đổi chất của vi sinh vật theo nhiều cách khác nhau. Ví dụ, các ion bạc có thể ức chế hoạt động của enzym, đặc biệt là các ion có chứa lưu huỳnh. Khi làm như vậy, chúng có ảnh hưởng lớn đến quá trình chuyển hóa năng lượng của các vi sinh vật này.
Các sản phẩm có chứa bạc chứng tỏ mức độ hiệu quả kháng khuẩn rộng rãi, tuy nhiên, ít có hoạt động tấn công nấm hơn đáng kể so với vi khuẩn.
Hầu hết các ứng dụng đều là nơi có mối lo ngại về vi sinh vật (vi khuẩn, vi rút) phát triển khả năng chống lại chất kháng khuẩn hữu cơ.
Phân loại theo họ hóa học
Chất diệt khuẩn dựa trên Isothiazolinone là phổ biến nhất và loại này chứa nhiều hóa chất. Các dẫn xuất của isothiazolinone được sử dụng làm chất diệt khuẩn bao gồm:
- Methylisothiazolinone (MIT, MI)
- Chloromethylisothiazolinone (CMIT, CMI, MCI)
- Benzisothiazolinone (BIT)
- Octylisothiazolinone (OIT, OI)
- Dicholorooctylisothiazolinone (DCOIT, DCOI)
- Butylbenzisothiazolinone (BBIT)
Các sản phẩm BIT đã được sử dụng trong một số ứng dụng công nghiệp hạn chế cần bảo quản lâu dài để kiểm soát vi khuẩn.
Hỗn hợp của các chất diệt khuẩn trên thường được sử dụng
Gần đây hơn, một công nghệ vi nhũ tương mới đã được giới thiệu sử dụng 4,5-dichloro-2-n-octyl-4- isothiazolin-3-one (DCOIT)
|
Chemical Family |
Characteristics |
|
Formaldehyde/formalin and formaldehyde donors (e.g. Triazines) |
Mối quan tâm về môi trường nhưng vẫn được sử dụng do chi phí thấp |
|
Heavy metals (silver, mercury etc.) |
Một số bị hạn chế do độc hại và các mối quan tâm về môi trường |
|
Organosulfur; isothiazoline-based |
Kết hợp và sử dụng riêng biệt 5-clo-2-metyl4-isothiazolin-3-one (CIT) và 2-metyl-4- isothiazolin-3-one (MIT) và 1,2-benzisothiazolin-3-one (BIT) |
|
Organosulfur; pyridine derivatives |
Kẽm pyrithione có độ hòa tan thấp trong nước |
|
Others |
Axit và muối hữu cơ, hợp chất nitơ và phenol, glutaraldehyde, xyanobutan |
|
Blended formulations of the above |
Cho phép các công thức tùy chỉnh cho một sản phẩm, phạm vi chế biến và vi sinh vật cụ thể |
Một số chất diệt khuẩn phổ biến được sử dụng trong nhũ tương
BIT: 1,2-Benzisothiazolin-3-one (BIT) là một chất diệt khuẩn phổ rộng hiệu quả được sử dụng rộng rãi trong ngành công nghiệp phân tán polyme. Nó ổn định ở nhiệt độ lên đến 100 ° C. BIT cung cấp hiệu quả diệt khuẩn ở một phạm vi pH rộng (2-14).
MIT: Methylisothiazolinone (MIT) là một chất diệt khuẩn công nghiệp được sử dụng trong sơn, chất kết dính và các sản phẩm mỹ phẩm. Nó là một chất diệt khuẩn hiệu quả với hiệu quả diệt nấm hạn chế.
BIT / MIT: Sự kết hợp giữa BIT và MIT cung cấp một chất diệt khuẩn phổ rộng.
CMIT / MIT: Hỗn hợp ba-một của metylchloro-isothiazolinone (CMIT) và MIT thường được sử dụng làm chất diệt khuẩn trong phân tán polyme. CMIT / MIT là chất diệt khuẩn phổ rộng hoạt động trong khoảng 3-9 pH. Dung dịch kiềm làm suy giảm phân tử CMIT. CMIT cũng đã được xác định là chất gây mẫn cảm da ở mức trên 64 ppm.
FA-R: Chất diệt khuẩn giải phóng formaldehyde (FA-R) chủ yếu là chất diệt khuẩn, nhưng chúng có một số hiệu quả chống lại các sinh vật nấm ở liều lượng cao hơn.
Từ khóa:
mdichemical, phụ gia ngành sơn, chất bảo quản, phụ gia chống rêu mốc cho sơn, phụ gia chống thối cho sơn nước, coating additives
THÔNG TIN LIÊN HỆ:
CTY TNHH ĐẦU TƯ VÀ PHÁT TRIỂN THỊ TRƯỜNG HÓA CHẤT (MDI CHEMICAL CO., LTD)
KV Miền Nam: (+84) 28 6256 5573
KV Miền Bắc: (+84) 24 3747 2977
Hotline: (+84) 902 100 571
Website: www.mdi.vn
Email: sales@mdi.vn


